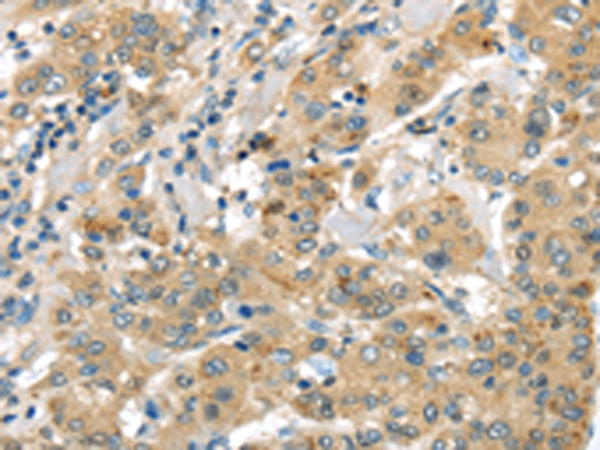

|
Background: |
Potent vasoconstrictor.Human Urotensin II is composed of only 11 amino acid residues, while fish and frog Urotensin II possess 12 and 13 amino acid residues, respectively (2). Human Urotensin II is found within both vascular and cardiac tissue, including coronary atheroma, and effectively constricts isolated arteries from nonhuman primates (3). Urotensin II may act as an autocrine and/or paracrine hormone rather than as a circulating hormone, by playing an important role in the development of ventricular hypertrophy induced by chronic hypoxia (4). |
|
Applications: |
ELISA, WB, IHC |
|
Name of antibody: |
UTS2B |
|
Immunogen: |
Synthetic peptide of humanUTS2B |
|
Full name: |
urotensin 2B |
|
Synonyms: |
U2B; URP; UTS2D |
|
SwissProt: |
Q765I0 |
|
ELISA Recommended dilution: |
2000-5000 |
|
IHC positive control: |
Human liver cancer |
|
IHC Recommend dilution: |
25-100 |
|
WB Predicted band size: |
14 kDa |
|
WB Positive control: |
A431 cells and Human liver cancer tissue, Lovo and PC3 cells, Human placenta tissue and 293T cells |
|
WB Recommended dilution: |
500-2000 |

購物車
購物車 幫助
幫助
 021-54845833/15800441009
021-54845833/15800441009
